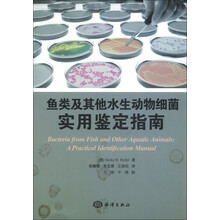

[书籍] 鱼类及其他水生动物细菌:实用鉴定指南
出版社:
海洋出版社
简介:
《鱼类及其他水生动物细菌:实用鉴定指南》提供了在水生动物(包括海水的和淡水的,特别是鱼类)中所发现细菌的鉴定方法,重点介绍了分离于养殖水生动物细菌的鉴定。内容包括对细菌的生化鉴定试验、生化反应组合、生化鉴定表及鉴定技术的阐释,同时介绍了细菌的分子鉴定技术。这是一本对兽医科学、水产养殖、动物健康研究人员和诊断专家以及微生物学家非常有用的、不可多得的工具书。
用户推荐(0)
暂无推荐,你也可以发布推荐哦:)
登录 | 立即注册